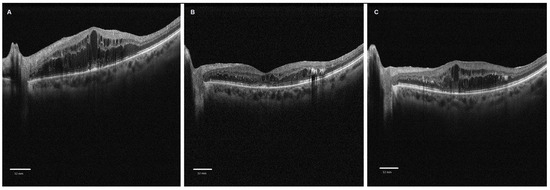

Abstract
Diabetes mellitus (DM) significantly impacts ocular health, particularly the retina and choroid, leading to diabetic retinopathy (DR) and diabetic macular edema (DME). This study aimed to evaluate the effects of intravitreal dexamethasone (IVD) on the choroidal vascularity index (CVI) in order to evaluate its potential as a biomarker. This was a retrospective observational study in which 37 eyes with DME treated with IVD were included. Baseline and follow-up (2 and 4 months post-injection) comprehensive ophthalmological examinations and spectral domain optical coherence tomography (SD-OCT) were performed. The CVI, luminal area (LA), stromal area (SA), and total area (TA) were assessed. No statistically significant changes in CVI, LA, SA, and TA were observed in the overall patient sample from baseline to 2 and 4 months post-IVD injection. However, a significant CVI reduction was noted in responder patients at 4 months. Positive correlations were found between the CVI and central macular thickness (CMT) at 2 months, suggesting that higher CMT values are associated with higher CVI values. This study indicated that IVD influences choroidal circulation, as evidenced by CVI reduction in responder patients. The CVI could potentially serve as an objective biomarker for treatment response in DME. Larger, prospective studies are warranted to clarify these findings further.
1. Introduction
Diabetes mellitus (DM) is a widespread chronic disease that affects approximately 537 million people worldwide, and its prevalence is increasing [1]. It significantly impacts the eyes, especially the retina and choroidal tissue. A major cause of vision loss is diabetic retinopathy (DR), which is estimated to affect up to 35% of diabetes patients. The development of DR is primarily linked to dysfunction in the retinal blood vessels and the breakdown of the blood–retinal barrier (BRB) [2].
The choroid, which supplies about 95% of the blood to the retina and provides oxygen and nutrients to its outer third, has become a key area of study in understanding the vascular implications of DM. Recent investigations, in vivo and in vitro, have deepened the understanding of choroidal vascular changes at the onset of DR [3,4,5,6,7,8]. The term “diabetic choroidopathy” describes changes such as small aneurysms, abnormal deposits on Bruch’s membrane, specific white blood cells in the choriocapillaris, and the formation of choroidal neovascularization [3,4,5]. Histopathological studies have confirmed alterations in the choroid due to DM progression, particularly showing changes in the choriocapillaris and large choroidal vessels even before the initial clinical signs of DR emerge. These alterations begin at the cellular metabolic level, with changes such as reduced expression of alkaline phosphatase, increased nitric oxide synthase, and increased leukocyte adhesion molecules, and later become visible at the vascular and stromal choroidal level, including a loss of choroidal endothelial cells, blockage of choriocapillaris vessels, and the presence of polymorphonuclear neutrophils in the choroidal stroma [6,7,8]. All of these changes contribute to the breakdown of the external BRB, representing both the cause and result of the formation of diabetic macular edema (DME) and DR, inducing impaired photoreceptor function and survival. DME is currently the principal motive for visual impairment in DR [2]. Numerous recent studies have focused on identifying biomarkers to assess the efficacy and response to treatment for this condition, including intravitreal anti-VEGF injections and intravitreal corticosteroid injections. The preferred treatment, according to international guidelines [9], for conditions where anti-VEGF use is not recommended (e.g., vitrectomized patients, patients with cardiac conditions) involves the intravitreal injection of a slow-release 0.7 mg dexamethasone implant (Ozurdex, Allergan; Irvine, CA, USA). Additionally, in patients who are non-responders to other treatment, it is used as a second-line therapy [9,10,11].
The introduction of optical coherence tomography (OCT) in recent decades has provided an accurate imaging tool for studying macular pathology and identifying disease biomarkers and therapeutic responses [12]. Enhanced-depth imaging–OCT (EDI-OCT) has recently advanced the understanding of choroidal changes and their role in DME onset and therapeutic response. Lately, considerable research has been dedicated to studying changes in the choroid related to systemic and ocular diseases, especially focusing on choroidal thickness (CT). At present, there is no consensus on CT variation in patients treated with intravitreal dexamethasone [13,14,15,16,17], possibly due to the poor reliability of the parameter, which is closely dependent on confounding factors such as patient age, gender, refractive error, and the presence of concurrent systemic and ocular pathologies [18,19]. The choroidal vascularity index (CVI) is a relatively novel value recently introduced into the study of choroidal vascularization. This parameter is obtained from the ratio between the choroidal luminal area (LA) and the total area (TA). The CVI has been shown to be more reliable and less dependent on external factors [20,21]. Several authors have studied the behavior of the CVI in diabetic patients and patients with DR, and there is a general consensus on the reduction of the parameter in affected patients. Duran et al. [22] and Aksoy et al. [23] conducted studies in patients with type 1 DM with no ophthalmological alterations and reported that the CVI was significantly reduced in affected patients versus a control group. Aksoy et al. hypothesized that these results may be justified by vascular narrowing secondary to choroidal hypoxia [23]. Kim et al. reported that the CVI was reduced in patients presenting with type 2 DM, with values related to the progression of DR [17]. Thus, it has been established that the CVI is lower in patients with diabetes (with or without DR) compared to age-matched healthy individuals. However, the impact of intravitreal dexamethasone therapy on these parameters is still being debated and could be used as a biomarker to assess the anatomical and functional response to treatment. The principal objective of our investigation was to evaluate the CVI in patients with DME before and after receiving the intravitreal dexamethasone injection, in accordance with international guidelines. We also evaluated alterations in LA, stromal area (SA), and TA to understand how dexamethasone affected diabetes-induced alteration of the choroid. Additionally, we sought to correlate these parameters with treatment response, as indicated by central macular thickness (CMT).
2. Materials and Methods
2.1. Study Design
This retrospective observational investigation included patients examined at the retina center of the UOD Ophthalmology of Sapienza University, Sant’Andrea Hospital. We enrolled 37 eyes of 37 patients with non-proliferative diabetic retinopathy (NPDR) and DME characterized by a central retinal thickness greater than 300 microns and new or recent-onset DME. Exclusion criteria included proliferative diabetic retinopathy with retinal neovascularization or previous laser photocoagulation treatment, other ocular pathologies inducing macular edema (e.g., retinal vein occlusion, age-related macular degeneration, uveitis, epiretinal membrane, vitreomacular traction), a spherical equivalent greater than 3 diopters, and previous intraocular surgery (within 6 months before the dexamethasone injection). This study received Institutional Review Board approval from the University of Rome, Sapienza. All patients enrolled gave their consent to participate in this study in accordance with the tenets of the Declaration of Helsinki.
All patients underwent a baseline visit and follow-up visits at 2 and 4 months post-injection, including a comprehensive ophthalmological examination with best corrected visual acuity (BCVA) measurement, spherical equivalent measurement, intraocular pressure assessment, anterior segment evaluation via slit-lamp, and fundus examination. Spectral domain optical coherence tomography (SD-OCT, Solix, Optovue, Inc., Fremont, CA, USA) was carried out after pharmacologically induced mydriasis with tropicamide 1% eye drops. Figure 1 represents cross-sectional SD-OCT scans centered on the fovea of a diabetic patient with diabetic macular edema at baseline and at 2 and 4 months from the dexamethasone intravitreal injection (Figure 1).
Figure 1.
Cross-sectional spectral domain optical coherence tomography scans centered on the fovea of a diabetic patient with diabetic macular edema treated with an intravitreal dexamethasone injection: (A) baseline scan; (B) 2-month follow-up scan; (C) 4-month follow-up scan.
2.2. OCT and Choroidal Vascularity Index
The SD-OCT assessment included raster scans, acquired with 17 parallel lines, and automated output retina map scans to identify CMT.
A horizontal cross-sectional centered raster scan of the fovea was selected for each patient to calculate the CVI. Image binarization was performed using the ImageJ software (distributed by Fiji, https://imagej.net/Fiji/Downloads (accessed on 1 July 2024)) based on the technique illustrated by Sonoda et al. [20]. The region of interest (ROI) corresponding to the total choroidal area was selected in a 3 mm wide area centered on the fovea with the polygon tool, extending from the retinal pigment epithelium (RPE) to the choroidoscleral margin. Following the selection of three 100-micron choroidal vessels, binarization was performed using Niblack’s automatic local thresholding method (Figure 2).

Figure 2.
Spectral domain optical coherence tomography (SD-OCT) raster scan of a diabetic patient with diabetic macular edema. The binarized image of the 3 mm area centered on the fovea superimposed on the SD-OCT image, with the region of interest highlighted in yellow, corresponding to the choroidal area.
The software analysis identified dark pixel areas (LA) and the total number of pixels in the ROI (TA). The ratio of LA to TA determined the CVI. The SA was calculated by subtracting the LA from the total area (TA).
A cross-sectional scan centered on the fovea was selected to analyze the qualitative and quantitative features of retinal morphology at baseline, at two months, and four months follow-up after the intravitreal dexamethasone injection. Specifically, the following characteristics were assessed: subretinal fluid (SRF), defined as the presence of fluid beneath the neuroepithelium; disruption of the ellipsoid zone (EZ), measured by the transverse extent (in microns) of the loss of the characteristic hyperreflective EZ signal; the presence of disorganization of the retinal inner layers (DRIL); and the presence of hyperreflective foci (HRF). These assessments were performed using the ImageJ software.
2.3. Data Analysis
Statistical analysis was performed using IBM SPSS Statistics (version 27.0.1.0, Chicago, IL, USA). Data are reported as mean ± standard deviation for continuous variables or as the number of cases and percentages for categorical variables. All distributions were tested for normality using the Kolmogorov–Smirnov test. Differences between pre- and post-therapy values were calculated using ANOVA with repeated measures, and post hoc analysis was carried out with a Bonferroni correction. Multiple linear regression analysis explored the relationships between the variables. After adjustment when required, a p-value of less than 0.05 was considered statistically significant.
3. Results
A total of 37 eyes of 37 patients with NPDR and DME, of whom 12 were women and 25 were men, were enrolled according to the selection criteria. Thirty patients were treatment-naïve to intravitreal dexamethasone injections, while seven were switched from anti-VEGF therapy. Eight patients (five naïve patients and three switched from anti-VEGF) exhibited a poor response to intravitreal dexamethasone treatment and were classified as poor responders according to the criteria of Rodriguez-Valdes et al. [24] (Figure 1).
Data analysis did not reveal statistically significant differences in the parameters of CVI, LA, SA, and TA between baseline and the 2- and 4-month post-intravitreal dexamethasone follow-up (Table 1).

Table 1.
Choroidal analysis in the total sample at baseline and 2 and 4 months post-IVD.
Data were successively evaluated by repeating the analysis following the exclusion of the poor responders, and a statistically significant reduction in CVI was observed over the follow-up period (p = 0.049) (Table 2). Post hoc analysis revealed a statistically significant reduction in CVI at 4 months post-intravitreal dexamethasone compared to baseline, but not compared to 2 months post-intravitreal dexamethasone (Table 3). No statistically significant differences emerged in analyzing the dexamethasone responders regarding LA, SA, and TA parameters. However, in absolute values, we observed a decrease in LA and an increase in SA values throughout the follow-up period; TA showed a decrease at 2 months post-intravitreal dexamethasone with an increase at 4 months post-intravitreal dexamethasone.

Table 2.
Choroidal analysis in intravitreal dexamethasone responder patients at baseline and 2 and 4 months post-IVD.

Table 3.
Post hoc analysis on CVI in IVD responder patients.
Univariate regression analysis between the CVI and CMT at 2 months post-intravitreal dexamethasone showed a positive correlation between the two values, both in the total sample patient analysis (n = 37, β = 0.463, r2 = 0.215, p = 0.004) and in the responder patient sample analysis (n = 29, β = 0.706, r2 = 0.498, p < 0.001). Moreover, there was a positive correlation between baseline CVI and CMT at 2 months following intravitreal dexamethasone; this emerged both in the total sample patient analysis (n = 37, β = 0.379, r2 = 0.144, p = 0.02) and was more significant in the analysis of the responder patient group (n = 29, β = 0.713, r2 = 0.509, p < 0.001). No other correlations were found.
Univariate regression analysis between retinal morphological parameters and the CVI at 2 and 4 months revealed no statistically significant correlations between the parameters. However, the multiple linear regression, which included CMT as an additional variable, confirmed the statistical significance of CMT in influencing the CVI at 2 months post-intravitreal injection.
Table 4 summarizes the descriptive characteristics of the retinal morphological parameters analyzed at baseline, 2 months, and 4 months of follow-up after the intravitreal dexamethasone injection.

Table 4.
Descriptive features of retinal morphological parameters at baseline, 2 months, and 4 months after intravitreal dexamethasone (IVD) injection.
4. Discussion
This study showed that subjects with DME who received an intravitreal dexamethasone injection did not show changes in CVI, TA, LA, and SA from baseline to the 2- and 4-month post-injection follow-ups. However, among the responsive patients, there was a notable decrease in CVI, with the most significant change occurring at 4 months post-injection. Considering that the objective of intravitreal dexamethasone injection is to decrease intra- and subretinal edema, and consequently reduce CMT, we considered this result to be the most significant in interpreting our data.
Previous studies explored the impact of diabetes on the choroid, revealing that the CVI is altered in affected patients [17,22,23,25]. This is reported to be due to microscopic and macroscopic changes caused by diabetes at cellular and vascular levels, such as vessel narrowing with focal dilation of vessels, vascular permeability increase, pro-inflammatory cytokine production, and polymorphonuclear stromal cells, with gradual alteration of choroidal tissue [26,27]. These alterations impact the CVI, causing structural changes in both the choroidal vessel lumen and the choroidal stroma. Kase et al. showed TA, SA, and LA increases, which were statistically significant, in diabetic patients with central-involving DME versus patients with DR in the absence of DME, while observing no difference in the CVI [25]. The authors suggested that these changes could be responsible for the onset of DME. They suggested that the increase in choroidal tissue volume, resulting from vasodilation, production of humoral factors, and accumulation of advanced glycation end products in the choroidal stroma, induced an increase in choroidal pressure [25,28]. This increased pressure, in turn, could cause mechanical stress on the RPE cells, leading to altered RPE cell polarity and secretion of factors into the sensory retina [25].
The intravitreal injection of dexamethasone is known to be beneficial for DME by reducing intraretinal edema and resolving neuroepithelial detachment. This treatment is particularly effective in cases where inflammatory factors are prominent, as indicated by biomarkers such as hyper-reflective dots, subfoveal serous retinal detachment, and alterations in the external limiting membrane and ellipsoid zone integrity [29].
Corticosteroids have several effects that help reduce inflammation in the eye. They limit the recruitment of pro-inflammatory cells, suppress the production of inflammatory cytokines such as VEGF, inhibit the action of nitric oxide synthase, and prevent the release of histamine and prostaglandin. Additionally, they improve the function of the BRB by acting on the tight junctions of endothelial cells. These effects impact the vascular and tissue levels in both the retina and choroid [17].
In the literature, there are limited studies in which the effect of an intravitreal dexamethasone injection on the CVI for DME in diabetic patients is explored. Rishi et al., in a study on DME patients managed with intravitreal dexamethasone, both naïve and previously treated with anti-VEGF injections, found no differences in choroidal thickness and CVI at 10 weeks post-injection [30]. Bilici et al. also did not find any differences [31]. These results align with our study where we did not find any difference in the CVI in the total analyzed sample. However, in our study, patients who were dexamethasone responders, with a reduction in CMT, had a significantly lower CVI following treatment as compared to baseline. Kocamiş et al. showed a significant reduction in CVI and LA in the third month post-dexamethasone injection in patients with DME resistant to anti-VEGF therapy. The authors attributed these results to a reduction in vasodilation induced by the local effects of the corticosteroid [32]. In our study, although not statistically significant, we also observed a progressive reduction in LA during the follow-up, confirming the local effects of the corticosteroid, albeit limited. Therefore, we agree with these authors that the reduction in LA in our study could potentially be attributed to the effects of corticosteroids on choroidal vasculature.
Similar results emerged from the recent study by İlgüy et al., who reported a reduction in LA, TA, and CVI in the third month post-intravitreal dexamethasone injection in patients with DME refractory to anti-VEGF. These authors observed a progressive decrease in LA, TA, and CVI values during follow-up and hypothesized that this trend could be explained by the pharmacokinetics of intravitreal dexamethasone [33]. Animal model studies showed that dexamethasone reaches peak concentration in the second month after intravitreal injection and becomes undetectable after the 180th day [33,34]. Even in our study, CVI decreased significantly in the fourth month after intravitreal injection, suggesting a prolonged action of dexamethasone on the choroid even after the second month.
In our study, we also found a positive correlation between the CVI and CMT in the second month, suggesting that higher CMT values are associated with higher CVI values. It is reasonable to hypothesize that this behavior is related to the response to intravitreal dexamethasone; in responder patients, there is a greater reduction in CVI and vice versa. Interestingly, a correlation emerged between baseline CVI and CMT in the second month. We could speculate that higher baseline CVI may suggest a greater acute inflammatory response at the choroidal level, which is reasonably associated with greater difficulty for dexamethasone to induce complete fluid reabsorption. Our results contrast with those of İlgüy et al., who reported a greater reduction in CMT in patients with high baseline CVI, with a moderately significant relationship [32]. However, we are only the second group to study this relationship, and our analyzed population sample differs from that of İlgüy et al., who included patients with DME refractory to anti-VEGF, whereas the majority of patients in our sample were treatment-naïve patients.
The effect of intravitreal injections on the CVI has been explored to a limited extent, even in the context of anti-VEGF therapy. Toprak et al. reported a reduction in CVI at three and six months following the intravitreal injection of anti-VEGF [35]. Dou et al. conducted a study investigating both the effect of anti-VEGF on CVI and the prognostic value of baseline CVI in predicting a functional response to intravitreal injection. Their findings demonstrated that patients with a higher baseline CVI tended to achieve greater visual acuity gains regarding letter scores compared to those with a lower baseline CVI. The authors also included in their analysis the influence of retinal morphological parameters related to inflammation, such as the presence of subretinal fluid (SRF), the number of hyperreflective foci (HRF), the extent of disruption of the inner limiting membrane and ellipsoid zone (EZ), and the presence of disorganization of the retinal inner layers (DRIL), on visual recovery post-intravitreal anti-VEGF injection in relation to the CVI. Overall, they demonstrated that an increased reflectivity of the EZ, the presence of SRF, and the absence of DRIL at baseline are associated with greater functional recovery following intravitreal injection [36].
In the present study, we did not assess functional visual outcomes. However, we aimed to analyze and integrate qualitative and quantitative retinal biomarkers indicative of inflammation [37], evaluating their influence on inducing changes in choroidal and retinal vascularization, specifically in relation to the CVI. Our statistical analysis did not show any significant influence of these inflammatory parameters on the CVI. The reason for this observation is unclear and remains a relationship that has not yet been explored in the literature. A potential explanation for the independence of the CVI from inflammatory biomarkers in our study, despite intravitreal dexamethasone injections, could be that the inflammatory parameters remained largely stable without statistically significant changes, unlike CMT, which did exhibit expected variations following intravitreal dexamethasone treatment.
Further studies are needed to investigate this relationship more deeply and to clarify the potential role of the CVI as a marker for inflammatory changes in retinal conditions following different therapeutic interventions.
Our study has some limitations: the retrospective design, the relatively small sample size, and the short follow-up time.
In the present study, we did not include systemic health variables, such as glycated hemoglobin (HbA1c), average blood pressure, or lipid profiles of the analyzed patients. These factors are known to influence systemic and microvascular circulation, potentially affecting vascular health. Elevated blood glucose, poor blood pressure control, and dyslipidemia can all contribute to endothelial dysfunction, increased vascular inflammation, and oxidative stress, which are key mechanisms in the pathogenesis of diabetic vascular complications [38,39]. These systemic factors may also affect the choroidal vasculature and, consequently, the CVI [40,41]. However, data specifically linking these parameters to CVI changes, particularly in response to intravitreal dexamethasone treatment, are currently limited.
In conclusion, the CVI, as previously shown, is a reliable and repeatable parameter for evaluating the vascular and structural features of the choroid. It tends to decrease in diabetic patients in direct proportion to disease severity. The reduction in CVI in diabetic patients with DME treated with intravitreal dexamethasone suggests that the therapy influences choroidal circulation. The CVI could potentially serve as an objective biomarker for treatment response in DME. However, further investigations with larger prospective studies with longer follow-up periods are needed to clarify the choroidal changes caused by intravitreal dexamethasone implants.
Author Contributions
Conceptualization, M.D.P. and S.A.; methodology, M.D.P., D.F. and E.M.; resources, M.D.P. and F.R.; data curation, D.F., E.M. and S.A.; writing—original draft preparation, M.D.P., F.R. and E.M.; writing—review and editing, D.F. and S.A.; visualization, M.D.P. and D.F.; supervision, M.D.P. and S.A. All authors have read and agreed to the published version of the manuscript.
Funding
This research received no external funding.
Institutional Review Board Statement
This study was conducted in accordance with the Declaration of Helsinki and approved by the Institutional Review Board of Sapienza University n°5602/2020, (15/09/2020).
Informed Consent Statement
Informed consent was obtained from all subjects involved in this study. Written informed consent has been obtained from the patients to publish this paper.
Data Availability Statement
The original contributions presented in the study are included in the article, further inquiries can be directed to the corresponding author.
Conflicts of Interest
The authors declare no conflicts of interest.
References
- Hossain, M.J.; Al-Mamun, M.; Islam, M.R. Diabetes Mellitus, the Fastest Growing Global Public Health Concern: Early Detection Should Be Focused. Health Sci. Rep. 2024, 7, e2004. [Google Scholar] [CrossRef] [PubMed]
- Zhang, J.; Zhang, J.; Zhang, C.; Zhang, J.; Gu, L.; Luo, D.; Qiu, Q. Diabetic Macular Edema: Current Understanding, Molecular Mechanisms and Therapeutic Implications. Cells 2022, 11, 3362. [Google Scholar] [CrossRef] [PubMed]
- Campos, A.; Campos, E.J.; Martins, J.; Ambrósio, A.F.; Silva, R. Viewing the Choroid: Where We Stand, Challenges and Contradictions in Diabetic Retinopathy and Diabetic Macular Oedema. Acta Ophthalmol. 2017, 95, 446–459. [Google Scholar] [CrossRef] [PubMed]
- Lutty, G.A. Diabetic Choroidopathy. Vis. Res. 2017, 139, 161–167. [Google Scholar] [CrossRef]
- Scuderi, L.; Fragiotta, S.; Di Pippo, M.; Abdolrahimzadeh, S. The Role of Diabetic Choroidopathy in the Pathogenesis and Progression of Diabetic Retinopathy. Int. J. Mol. Sci. 2023, 24, 10167. [Google Scholar] [CrossRef]
- Hidayat, A.A.; Fine, B.S. Diabetic Choroidopathy. Light and Electron Microscopic Observations of Seven Cases. Ophthalmology 1985, 92, 512–522. [Google Scholar] [CrossRef]
- Lutty, G.A.; Cao, J.; McLeod, D.S. Relationship of Polymorphonuclear Leukocytes to Capillary Dropout in the Human Diabetic Choroid. Am. J. Pathol. 1997, 151, 707–714. [Google Scholar]
- Yang, C.-J.; Nguyen, D.D.; Lai, J.-Y. Poly(l-Histidine)-Mediated On-Demand Therapeutic Delivery of Roughened Ceria Nanocages for Treatment of Chemical Eye Injury. Adv. Sci. 2023, 10, e2302174. [Google Scholar] [CrossRef]
- Schmidt-Erfurth, U.; Garcia-Arumi, J.; Bandello, F.; Berg, K.; Chakravarthy, U.; Gerendas, B.S.; Jonas, J.; Larsen, M.; Tadayoni, R.; Loewenstein, A. Guidelines for the Management of Diabetic Macular Edema by the European Society of Retina Specialists (EURETINA). Ophthalmologica 2017, 237, 185–222. [Google Scholar] [CrossRef]
- Boyer, D.S.; Faber, D.; Gupta, S.; Patel, S.S.; Tabandeh, H.; Li, X.-Y.; Liu, C.C.; Lou, J.; Whitcup, S.M.; Ozurdex CHAMPLAIN Study Group. Dexamethasone Intravitreal Implant for Treatment of Diabetic Macular Edema in Vitrectomized Patients. Retina 2011, 31, 915–923. [Google Scholar] [CrossRef]
- Lazic, R.; Lukic, M.; Boras, I.; Draca, N.; Vlasic, M.; Gabric, N.; Tomic, Z. Treatment of Anti-Vascular Endothelial Growth Factor-Resistant Diabetic Macular Edema with Dexamethasone Intravitreal Implant. Retina 2014, 34, 719–724. [Google Scholar] [CrossRef] [PubMed]
- Meduri, A.; Oliverio, G.W.; Trombetta, L.; Giordano, M.; Inferrera, L.; Trombetta, C.J. Optical Coherence Tomography Predictors of Favorable Functional Response in Naïve Diabetic Macular Edema Eyes Treated with Dexamethasone Implants as a First-Line Agent. J. Ophthalmol. 2021, 2021, 6639418. [Google Scholar] [CrossRef] [PubMed]
- Vujosevic, S.; Martini, F.; Cavarzeran, F.; Pilotto, E.; Midena, E. Macular and Peripapillary Choroidal Thickness in Diabetic Patients. Retina 2012, 32, 1781–1790. [Google Scholar] [CrossRef] [PubMed]
- Unsal, E.; Eltutar, K.; Zirtiloğlu, S.; Dinçer, N.; Ozdoğan Erkul, S.; Güngel, H. Choroidal Thickness in Patients with Diabetic Retinopathy. Clin. Ophthalmol. 2014, 8, 637–642. [Google Scholar] [CrossRef]
- Xu, J.; Xu, L.; Du, K.F.; Shao, L.; Chen, C.X.; Zhou, J.Q.; Wang, Y.X.; You, Q.S.; Jonas, J.B.; Wei, W.B. Subfoveal Choroidal Thickness in Diabetes and Diabetic Retinopathy. Ophthalmology 2013, 120, 2023–2028. [Google Scholar] [CrossRef]
- Querques, G.; Lattanzio, R.; Querques, L.; Del Turco, C.; Forte, R.; Pierro, L.; Souied, E.H.; Bandello, F. Enhanced Depth Imaging Optical Coherence Tomography in Type 2 Diabetes. Invest. Ophthalmol. Vis. Sci. 2012, 53, 6017–6024. [Google Scholar] [CrossRef]
- Kim, J.T.; Lee, D.H.; Joe, S.G.; Kim, J.-G.; Yoon, Y.H. Changes in Choroidal Thickness in Relation to the Severity of Retinopathy and Macular Edema in Type 2 Diabetic Patients. Investig. Ophthalmol. Vis. Sci. 2013, 54, 3378–3384. [Google Scholar] [CrossRef]
- Xie, J.; Ye, L.; Chen, Q.; Shi, Y.; Hu, G.; Yin, Y.; Zou, H.; Zhu, J.; Fan, Y.; He, J.; et al. Choroidal Thickness and Its Association with Age, Axial Length, and Refractive Error in Chinese Adults. Investig. Ophthalmol. Vis. Sci. 2022, 63, 34. [Google Scholar] [CrossRef]
- Di Pippo, M.; Santia, C.; Rullo, D.; Ciancimino, C.; Grassi, F.; Abdolrahimzadeh, S. The Choroidal Vascularity Index Versus Optical Coherence Tomography Angiography in the Evaluation of the Choroid with a Focus on Age-Related Macular Degeneration. Tomography 2023, 9, 1456–1470. [Google Scholar] [CrossRef]
- Sonoda, S.; Sakamoto, T.; Yamashita, T.; Uchino, E.; Kawano, H.; Yoshihara, N.; Terasaki, H.; Shirasawa, M.; Tomita, M.; Ishibashi, T. Luminal and Stromal Areas of Choroid Determined by Binarization Method of Optical Coherence Tomographic Images. Am. J. Ophthalmol. 2015, 159, 1123–1131.e1. [Google Scholar] [CrossRef]
- Agrawal, R.; Gupta, P.; Tan, K.-A.; Cheung, C.M.G.; Wong, T.-Y.; Cheng, C.-Y. Choroidal Vascularity Index as a Measure of Vascular Status of the Choroid: Measurements in Healthy Eyes from a Population-Based Study. Sci. Rep. 2016, 6, 21090. [Google Scholar] [CrossRef] [PubMed]
- Duran, M.; Cevher, S.; Kendirci, H.N.P. Choroidal Thickness and Choroidal Vascularity Index Changes in Children with Type 1 Diabetes Mellitus without Retinopathy. Photodiagnosis Photodyn. Ther. 2023, 43, 103706. [Google Scholar] [CrossRef] [PubMed]
- Aksoy, M.; Simsek, M.; Apaydın, M. Choroidal Vascularity Index in Patients with Type-1 Diabetes Mellitus without Diabetic Retinopathy. Curr. Eye Res. 2021, 46, 865–870. [Google Scholar] [CrossRef] [PubMed]
- Rodríguez-Valdés, P.J.; Rehak, M.; Zur, D.; Sala-Puigdollers, A.; Fraser-Bell, S.; Lupidi, M.; Chhablani, J.; Cebeci, Z.; Laíns, I.; Chaikitmongkol, V.; et al. GRAding of Functional and Anatomical Response to DExamethasone Implant in Patients with Diabetic Macular Edema: GRADE-DME Study. Sci. Rep. 2021, 11, 4738. [Google Scholar] [CrossRef]
- Kase, S.; Endo, H.; Takahashi, M.; Ito, Y.; Saito, M.; Yokoi, M.; Katsuta, S.; Sonoda, S.; Sakamoto, T.; Ishida, S.; et al. Alteration of Choroidal Vascular Structure in Diabetic Macular Edema. Graefe’s Arch. Clin. Exp. Ophthalmol. 2020, 258, 971–977. [Google Scholar] [CrossRef]
- Tan, K.-A.; Laude, A.; Yip, V.; Loo, E.; Wong, E.P.; Agrawal, R. Choroidal Vascularity Index—A Novel Optical Coherence Tomography Parameter for Disease Monitoring in Diabetes Mellitus? Acta Ophthalmol. 2016, 94, e612–e616. [Google Scholar] [CrossRef]
- Gupta, P.; Thakku, S.G.; Sabanayagam, C.; Tan, G.; Agrawal, R.; Cheung, C.M.G.; Lamoureux, E.L.; Wong, T.-Y.; Cheng, C.-Y. Characterisation of Choroidal Morphological and Vascular Features in Diabetes and Diabetic Retinopathy. Br. J. Ophthalmol. 2017, 101, 1038–1044. [Google Scholar] [CrossRef]
- Kase, S.; Ishida, S.; Rao, N.A. Immunolocalization of Advanced Glycation End Products in Human Diabetic Eyes: An Immunohistochemical Study. J. Diabetes Mellit. 2011, 1, 57–62. [Google Scholar] [CrossRef]
- Chi, S.-C.; Kang, Y.-N.; Huang, Y.-M. Efficacy and Safety Profile of Intravitreal Dexamethasone Implant versus Antivascular Endothelial Growth Factor Treatment in Diabetic Macular Edema: A Systematic Review and Meta-Analysis. Sci. Rep. 2023, 13, 7428. [Google Scholar] [CrossRef]
- Rishi, P.; Verma, A.; Akhtar, Z.; Agrawal, R.; Agrawal, A.; Kalluri Bharat, R.P.; Rishi, E. Intravitreal Ozurdex Has No Short Term Influence on Choroidal Thickness and Vascularity Index in Eyes with Diabetic Macular Edema: A Pilot Study. Oman J. Ophthalmol. 2021, 14, 179–183. [Google Scholar] [CrossRef]
- Bilici, S.; Serbest, E.; Ugurbas, S.H. Short-Term Effects of Intravitreal Dexamethasone Implant on Choroidal Structure in Eyes with Refractory Diabetic Macular Edema. Beyoglu Eye J. 2023, 8, 193–197. [Google Scholar] [CrossRef] [PubMed]
- Kocamiş, Ö.; Temel, E.; Özcan, G.; Aşikgarip, N.; Örnek, K. Choroidal Vascularity Index after a Single Dose of Intravitreal Dexamethasone Implant in Patients with Refractory Diabetic Macular Oedema. Photodiagnosis Photodyn. Ther. 2022, 39, 102996. [Google Scholar] [CrossRef] [PubMed]
- İlgüy, S.; Işık, M.U. Prognostic Value of Choroidal Vascular Index in Determining Response to Intravitreal Dexamethasone Implant Treatment Used in Refractory Diabetic Macular Edema. Lasers Med. Sci. 2023, 38, 47. [Google Scholar] [CrossRef] [PubMed]
- Chang-Lin, J.-E.; Attar, M.; Acheampong, A.A.; Robinson, M.R.; Whitcup, S.M.; Kuppermann, B.D.; Welty, D. Pharmacokinetics and Pharmacodynamics of a Sustained-Release Dexamethasone Intravitreal Implant. Investig. Ophthalmol. Vis. Sci. 2011, 52, 80–86. [Google Scholar] [CrossRef]
- Toprak, A.; Koc, H.; Alpay, A.; Ugurbas, S.H. The Effect of Intravitreal Anti-VEGF Injections on Choroidal Vascular Index in Patients with Diabetic Macular Edema. Cutan. Ocul. Toxicol. 2024, 43, 204–210. [Google Scholar] [CrossRef]
- Dou, N.; Yu, S.; Tsui, C.-K.; Yang, B.; Lin, J.; Lu, X.; Xu, Y.; Wu, B.; Zhao, J.; Liang, X. Choroidal Vascularity Index as a Biomarker for Visual Response to Antivascular Endothelial Growth Factor Treatment in Diabetic Macular Edema. J. Diabetes Res. 2021, 2021, 3033219. [Google Scholar] [CrossRef]
- Munk, M.R.; Somfai, G.M.; de Smet, M.D.; Donati, G.; Menke, M.N.; Garweg, J.G.; Ceklic, L. The Role of Intravitreal Corticosteroids in the Treatment of DME: Predictive OCT Biomarkers. Int. J. Mol. Sci. 2022, 23, 7585. [Google Scholar] [CrossRef]
- Naqvi, S.S.Z.H.; Imani, S.; Hosseinifard, H.; Wen, Q.-L.; Shahzad, M.N.; Ijaz, I.; Deng, Y.; Guo, M.; Xu, Y. Associations of Serum Low-Density Lipoprotein and Systolic Blood Pressure Levels with Type 2 Diabetic Patients with and without Peripheral Neuropathy: Systemic Review, Meta-Analysis and Meta-Regression Analysis of Observational Studies. BMC Endocr. Disord. 2019, 19, 125. [Google Scholar] [CrossRef]
- Xue, C.; Chen, K.; Gao, Z.; Bao, T.; Dong, L.; Zhao, L.; Tong, X.; Li, X. Common Mechanisms Underlying Diabetic Vascular Complications: Focus on the Interaction of Metabolic Disorders, Immuno-Inflammation, and Endothelial Dysfunction. Cell Commun. Signal. 2023, 21, 298. [Google Scholar] [CrossRef]
- Aşıkgarip, N.; Temel, E.; Kıvrak, A.; Örnek, K. Choroidal Structural Changes and Choroidal Vascularity Index in Patients with Systemic Hypertension. Eur. J. Ophthalmol. 2022, 32, 2427–2432. [Google Scholar] [CrossRef]
- Temel, E.; Özcan, G.; Yanık, Ö.; Demirel, S.; Batıoğlu, F.; Kar, İ.; Özmert, E. Choroidal Structural Alterations in Diabetic Patients in Association with Disease Duration, HbA1c Level, and Presence of Retinopathy. Int. Ophthalmol. 2022, 42, 3661–3672. [Google Scholar] [CrossRef]
Disclaimer/Publisher’s Note: The statements, opinions and data contained in all publications are solely those of the individual author(s) and contributor(s) and not of MDPI and/or the editor(s). MDPI and/or the editor(s) disclaim responsibility for any injury to people or property resulting from any ideas, methods, instructions or products referred to in the content. |
© 2024 by the authors. Licensee MDPI, Basel, Switzerland. This article is an open access article distributed under the terms and conditions of the Creative Commons Attribution (CC BY) license (https://creativecommons.org/licenses/by/4.0/).


